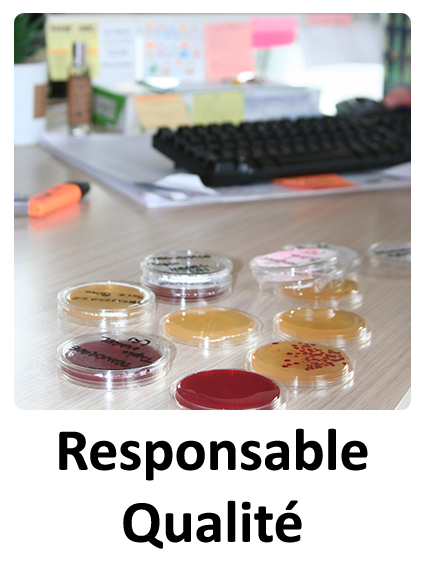

NOUS REJOINDRE

Entreprise familiale exerçant depuis 30ans dans le commerce de viande, nous sommes reconnus pour la qualité de nos produits et de nos services auprès des professionnels de l'alimentation. Nous souhaitons compléter nos équipes par des personnes fiables, responsables et stables. Étant une entreprise de taille humaine, nous pouvons offrir des possibilités d'évolution à nos collaborateurs.
NOS POSTES A POURVOIR :